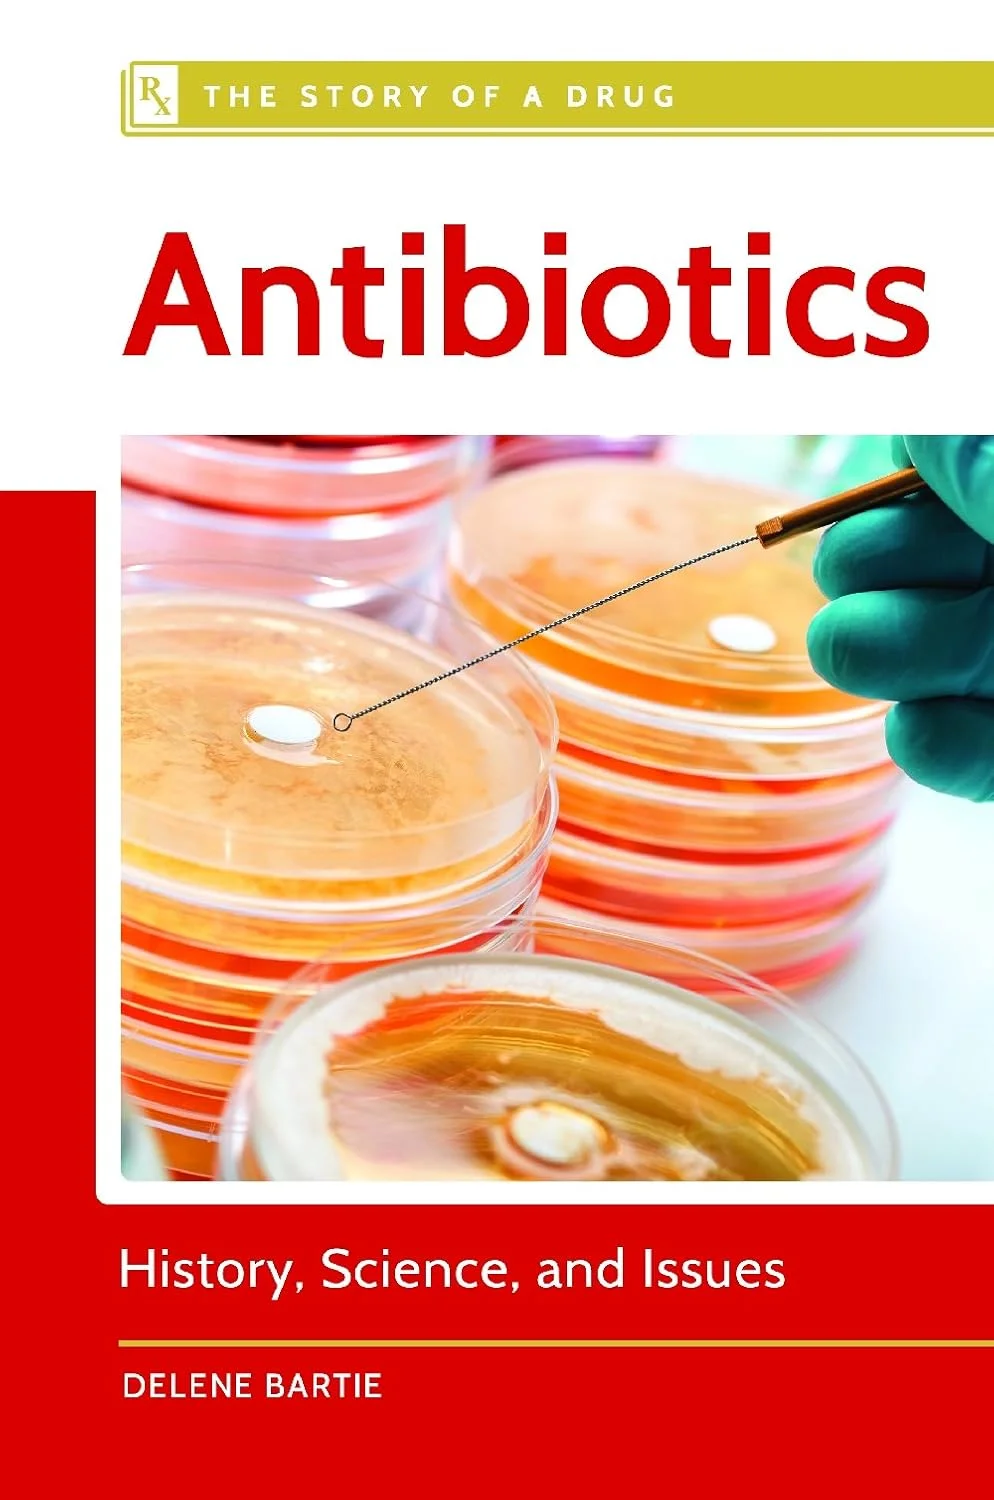
آنتی‌بیوتیک‌ها: تاریخچه، علم و مسائل

آنتی بیوتیک ها
فیلترها
آنتی بیوتیک ها یکی از اصلی ترین داروهای مورد استفاده در پزشکی نوین هستند که با هدف مقابله با عفونت های باکتریایی تجویز می شوند. این داروها با جلوگیری از رشد یا از بین بردن باکتری ها، نقش مؤثری در درمان بیماری هایی مانند عفونت های تنفسی، ادراری، پوستی و گوارشی ایفا می کنند. اما انتخاب درست، مصرف اصولی و آگاهی از عوارض آن ها امری بسیار حیاتی است. آنتی بیوتیک ها باید فقط تحت نظر پزشک مصرف شوند تا از مقاومت آنتی بیوتیکی و عوارض جانبی جلوگیری گردد.
با آنتی بیوتیک ها، سپری مطمئن در برابر باکتری ها بسازید
آنتی بیوتیک ها تنوع زیادی دارند و بر اساس نوع باکتری، شدت عفونت و محل درگیری بدن تجویز می شوند. از رایج ترین آن ها می توان به پنی سیلین ها، سفالوسپورین ها، ماکرولیدها، کینولون ها و تتراسایکلین ها اشاره کرد. این داروها ممکن است به شکل قرص، کپسول، شربت، آمپول یا قطره چشمی و گوشی موجود باشند. دوز مصرف، طول درمان و نوع مصرف بسته به نوع دارو و وضعیت بیمار متفاوت است. بعضی از آنها طیف گسترده ای دارند و برای انواع مختلفی از باکتری ها مؤثرند، در حالی که برخی دیگر صرفاً برای باکتری های خاص استفاده می شوند. رنگ، اندازه، برند تولیدکننده و نحوه ی ساخت (تأخیر رهش، فوری، جویدنی و...) از دیگر ویژگی های مهم این داروهاست.
راهنمای انتخاب آنتی بیوتیک ها بر اساس نوع عفونت و حساسیت
انتخاب صحیح آنتی بیوتیک ها مستلزم تشخیص دقیق نوع باکتری و محل عفونت است. برای مثال، در عفونت های دستگاه تنفسی فوقانی مانند سینوزیت یا گلودرد باکتریایی، داروهایی مانند آموکسی سیلین یا آزیترومایسین مؤثرند. در مقابل، برای عفونت های ادراری داروهایی نظیر نیتروفورانتوئین یا سیپروفلوکساسین تجویز می شود. سابقه حساسیت دارویی، سن بیمار، شرایط فیزیولوژیکی (مانند بارداری یا بیماری های کبدی و کلیوی) از عوامل مهم در انتخاب مناسب آنتی بیوتیک به شمار می آیند. مصرف خودسرانه این داروها می تواند منجر به مقاومت دارویی و عوارض جدی شود.
مزایای آنتی بیوتیک ها نسبت به درمان های سنتی
آنتی بیوتیک ها برخلاف درمان های سنتی، به صورت هدفمند و علمی علیه باکتری ها عمل می کنند. در حالی که روش های سنتی یا گیاهی عمدتاً تسکینی اند، آنهاا مستقیماً با عامل بیماری زا مقابله می کنند. داروهایی مانند سفیکسیم یا اریترومایسین می توانند در مدت زمانی کوتاه، عفونت را مهار کرده و از پیشرفت آن به ارگان های حیاتی جلوگیری کنند. علاوه بر اثربخشی بالا، امکان کنترل دوز و زمان دقیق مصرف را نیز دارند که دقت درمان را افزایش می دهد. همین ویژگی ها باعث شده که در بسیاری از موارد، تنها راه مقابله با بیماری های عفونی شدید، استفاده از آنتی بیوتیک ها باشد.
تنوع مدل های آنتی بیوتیک ها برای کاربردهای تخصصی
آنتی بیوتیک ها در مدل ها و اشکال متنوعی در بازار عرضه می شوند تا مناسب گروه های مختلف سنی و انواع خاصی از عفونت ها باشند. برای کودکان شربت هایی با طعم مناسب مانند آموکسی سیلین کودکان یا کوآموکسی کلاو طراحی شده اند. بزرگسالان می توانند از قرص و کپسول های متداول مانند آزیترومایسین، سفالکسین و مترونیدازول استفاده کنند. آمپول های تزریقی مانند جنتامایسین یا سفتریاکسون نیز برای عفونت های شدید یا بستری مورد استفاده قرار می گیرند. همچنین برخی از آنها به صورت موضعی (کرم یا پماد) برای درمان عفونت های پوستی یا چشمی تولید می شوند که این تنوع، امکان درمان دقیق تر و راحت تر را فراهم می سازد.
قیمت آنتی بیوتیک ها؛ از اقتصادی تا تخصصی
قیمت آنتی بیوتیک ها بسته به نوع ماده مؤثره، شرکت سازنده، وارداتی یا داخلی بودن و شکل دارویی (خوراکی، تزریقی، موضعی) متغیر است. داروهای رایجی مانند آموکسی سیلین و سفالکسین معمولاً قیمت اقتصادی تری دارند، در حالی که آنتی بیوتیک های خاص یا وارداتی مانند لینزولید یا تیگو سایکلین در دسته داروهای گران تر قرار می گیرند. با خرید از مراکز معتبر مانند فروشگاه اینترنتی کیان داریا، می توانید داروهای مورد نظر را با قیمت مناسب و اطمینان از کیفیت تهیه کنید. خرید اینترنتی همچنین امکان مقایسه بین محصولات و برندها را فراهم می سازد که در کاهش هزینه های درمانی مؤثر است.
راهنمای خرید آنتی بیوتیک ها با اطمینان از فروشگاه کیان داریا
اگر به دنبال خرید آسان و مطمئن هستید، فروشگاه کیان داریا یک انتخاب هوشمندانه است. تنوع بالا در محصولات، ارائه اطلاعات دقیق دارویی، فیلترهای پیشرفته برای جستجو، و نظرات کاربران به شما کمک می کند تا بهترین داروی متناسب با نیاز خود را انتخاب کنید. ارسال سریع، بسته بندی مناسب و مشاوره پیش از خرید نیز از جمله مزایای خرید از کیان داریا هستند. مهم تر از همه، شما می توانید با خیال راحت از اصالت دارو اطمینان حاصل کرده و درمانی مؤثر را آغاز کنید.
آنتی بیوتیک ها یکی از کلیدی ترین ابزارهای پزشکی مدرن برای مقابله با بیماری های باکتریایی هستند. شناخت نوع مناسب، مصرف اصولی و خرید از منبع معتبر مانند کیان داریا باعث می شود که این داروها با بیشترین اثربخشی و کمترین عارضه ممکن مصرف شوند. در مسیر سلامت، آگاهی و انتخاب صحیح، حرف اول را می زند.